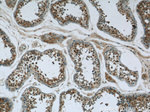
NCAPG Antibody in Immunohistochemistry (Paraffin) (IHC (P))

Search
Proteintech
NCAPG Polyclonal Antibody
{{$productOrderCtrl.translations['antibody.pdp.commerceCard.promotion.promotions']}}
{{$productOrderCtrl.translations['antibody.pdp.commerceCard.promotion.viewpromo']}}
{{$productOrderCtrl.translations['antibody.pdp.commerceCard.promotion.promocode']}}: {{promo.promoCode}} {{promo.promoTitle}} {{promo.promoDescription}}. {{$productOrderCtrl.translations['antibody.pdp.commerceCard.promotion.learnmore']}}

Please note: We are reviewing Western blot images included in the antibody testing data in our catalog, including those provided by third parties. Unless expressly labeled or annotated as “raw-unedited”, Western blot images included in the antibody testing data in our catalog may have been edited, optimized or otherwise adjusted for presentation.
产品信息
24563-1-AP
种属反应
已发表种属
宿主/亚型
分类
类型
抗原
偶联物
形式
浓度
规格
纯化类型
保存液
内含物
保存条件
运输条件
产品详细信息
Immunogen sequence: TLHCEGTEI NSDDEQESKE VEETATAKNV LKLLSDFLDS EVSELRTGAA EGLAKLMFSG LLVSSRILSR LILLWYNPVT EEDVQLRHCL GVFFPVFAYA SRTNQECFEE AFLPTLQTLA NAPASSPLAE IDITNVAELL VDLTRPSGLN PQAKTSQDYQ ALTVHDNLAM KICNEILTSP CSPEIRVYTK ALSSLELSSH LAKDLLVLLN EILEQVKDRT CLRALEKIKI QLEKGNKEFG DQAEAAQDAT LTTTTFQNED EKNKEVYMTP LRGVKATQAS KSTQLKTNRG QRKVTVSART NRRCQTAEAD SESDHEVPEP ESEMKMRLPR RAKTAALEKS KLNLAQFLNE DLS (664-1015 aa encoded by B C068467)
靶标信息
This gene encodes a subunit of the condensin complex, which is responsible for the condensation and stabilization of chromosomes during mitosis and meiosis. Phosphorylation of the encoded protein activates the condensin complex. There are pseudogenes for this gene on chromosomes 8 and 15. Alternative splicing results in multiple transcript variants.
仅用于科研。不用于诊断过程。未经明确授权不得转售。
生物信息学
蛋白别名: Chromosome-associated protein G; Condensin complex subunit 3; Condensin subunit CAP-G; FLJ12450; hCAP-G; Melanoma antigen NY-MEL-3; MGC126525; Non-SMC condensin I complex subunit G; XCAP-G homolog
基因别名: CAPG; NCAPG; NYMEL3
Entrez Gene ID: (Human) 64151




